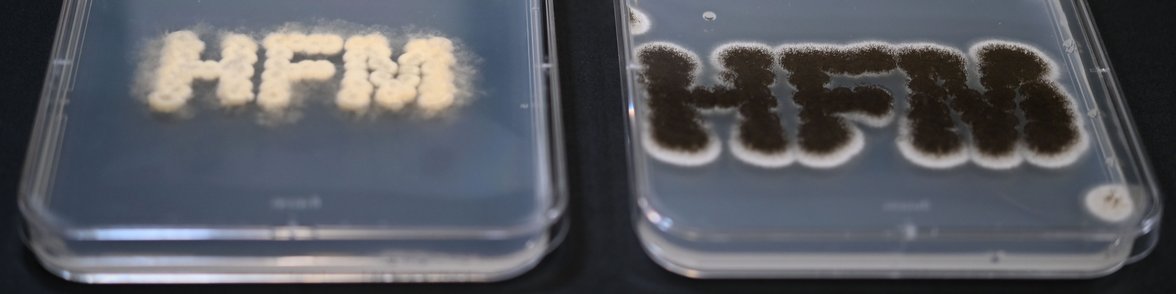

Professur für Pilz-Biotechnologie in der Holzwissenschaft
Das Forschungsgebiet der Professur sind die pilzlichen Abbauprozesse von pflanzlicher Biomasse mit dem Schwerpunkt Lignozellulosen, wie z.B. Holz. Diese sind von großem Interesse im Bereich der Entwicklung neuartiger Bioraffinerie-Konzepte basierend auf Neben- oder Abfallströmen der Forstindustrie, aber auch aus dem Lebensmittel und Agrarsektor. Wie Pilze auf molekularer Ebene die Zusammensetzung pflanzlicher Zellwände erkennen und dann ihren Metabolismus gezielt umstellen, um effektiv das Substrat zu zersetzen, sind zentrale Fragen, die in der Forschungsgruppe bearbeitet werden. Zum Einsatz kommen dabei modernste Methoden der Biochemie und Genetik. Ein weiterer Forschungsgegenstand ist die Nutzung der Myzelien von holzabbauenden Pilzen als eine Art “Bioklebstoff” zur Herstellung von pilzbasierten Kompositmaterialien. Besuchen sie unsere Forschungs-Seite, um mehr Informationen zu diesen spannenden Themen zu bekommen!
The Fungal Biotechnology group in the News
- Meat meets mushroom - a GFI-Interview about fungal mycelium as “scaffolds” for cultivated meat cells with Philipp, Yasmina & Felix
- Interview zum Wiederaufforstungsprojekt RESTORE mit dem BMBF
- ANTENNE BAYERN-Moderatorin Kathie Kleff im Gespräch mit Prof. J. Philipp Benz im „GET HAPPY!“ Podcast: Fantastische Pilze
- Forschung aus der Professur bei DokThema: Superhelden Pilze (BR DokThema)
- Ohne Pilzbiotechnologie keine zirkuläre Bioökonomie (BMBF Wissenschaftsjahr 2020/21)
- Wenn aus Pilzen Zukunft wird
- Pilze als Medizin? Warum Pilze wichtig für die Entwicklung von Antibiotika sind (ARD Alpha Campus Talks)
- New studies of the nutritional preferences of fungi provide a whole "buffet" of findings
- Ambrosia beetles nurture their gardens of fungus with alcohol (Science News)
- Why some beetles fly on alcohol
- The high diversity of fungal volatilomes